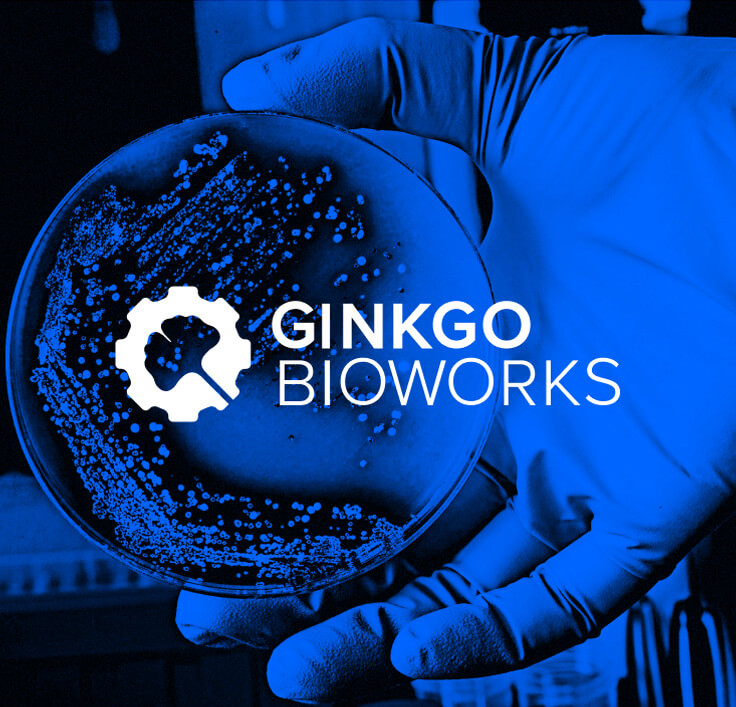

Friends don't let friends deliver bad service experiences.
Help them switch to Service Collection before it's too late.

DISCLAIMER
Service Collection leads to delightful service experiences, for employees and customers, powered by AI.

Balanced budgets
Reap unbelievable savings from lower licensing and implementation costs.

Connected teammates
Let Dev, IT, and business teams, like HR and customer service, work better together.

Instant resolutions
Provide quick relief with automated, AI-powered, and self-service support.

Faster setup
Respond to changes and incidents at high velocity.

Accelerated innovation with AI
Jump-start productivity with advanced AI agents, purpose-built for service work.

Elevated service
Create a better end-to-end service experience for everyone.
The ultimate service management solution, tried and tested
Studies show using Atlassian as directed for service management brings incredible results to Dev, IT, and business teams.

115
hours saved monthly for IT Ops*

15%
decrease in resolution time*

$2M
saved retiring legacy solutions*
*From a commissioned study conducted by Forrester Consulting on behalf of Atlassian.
Relief is at your fingertips

Try it for free
Switch to Service Collection